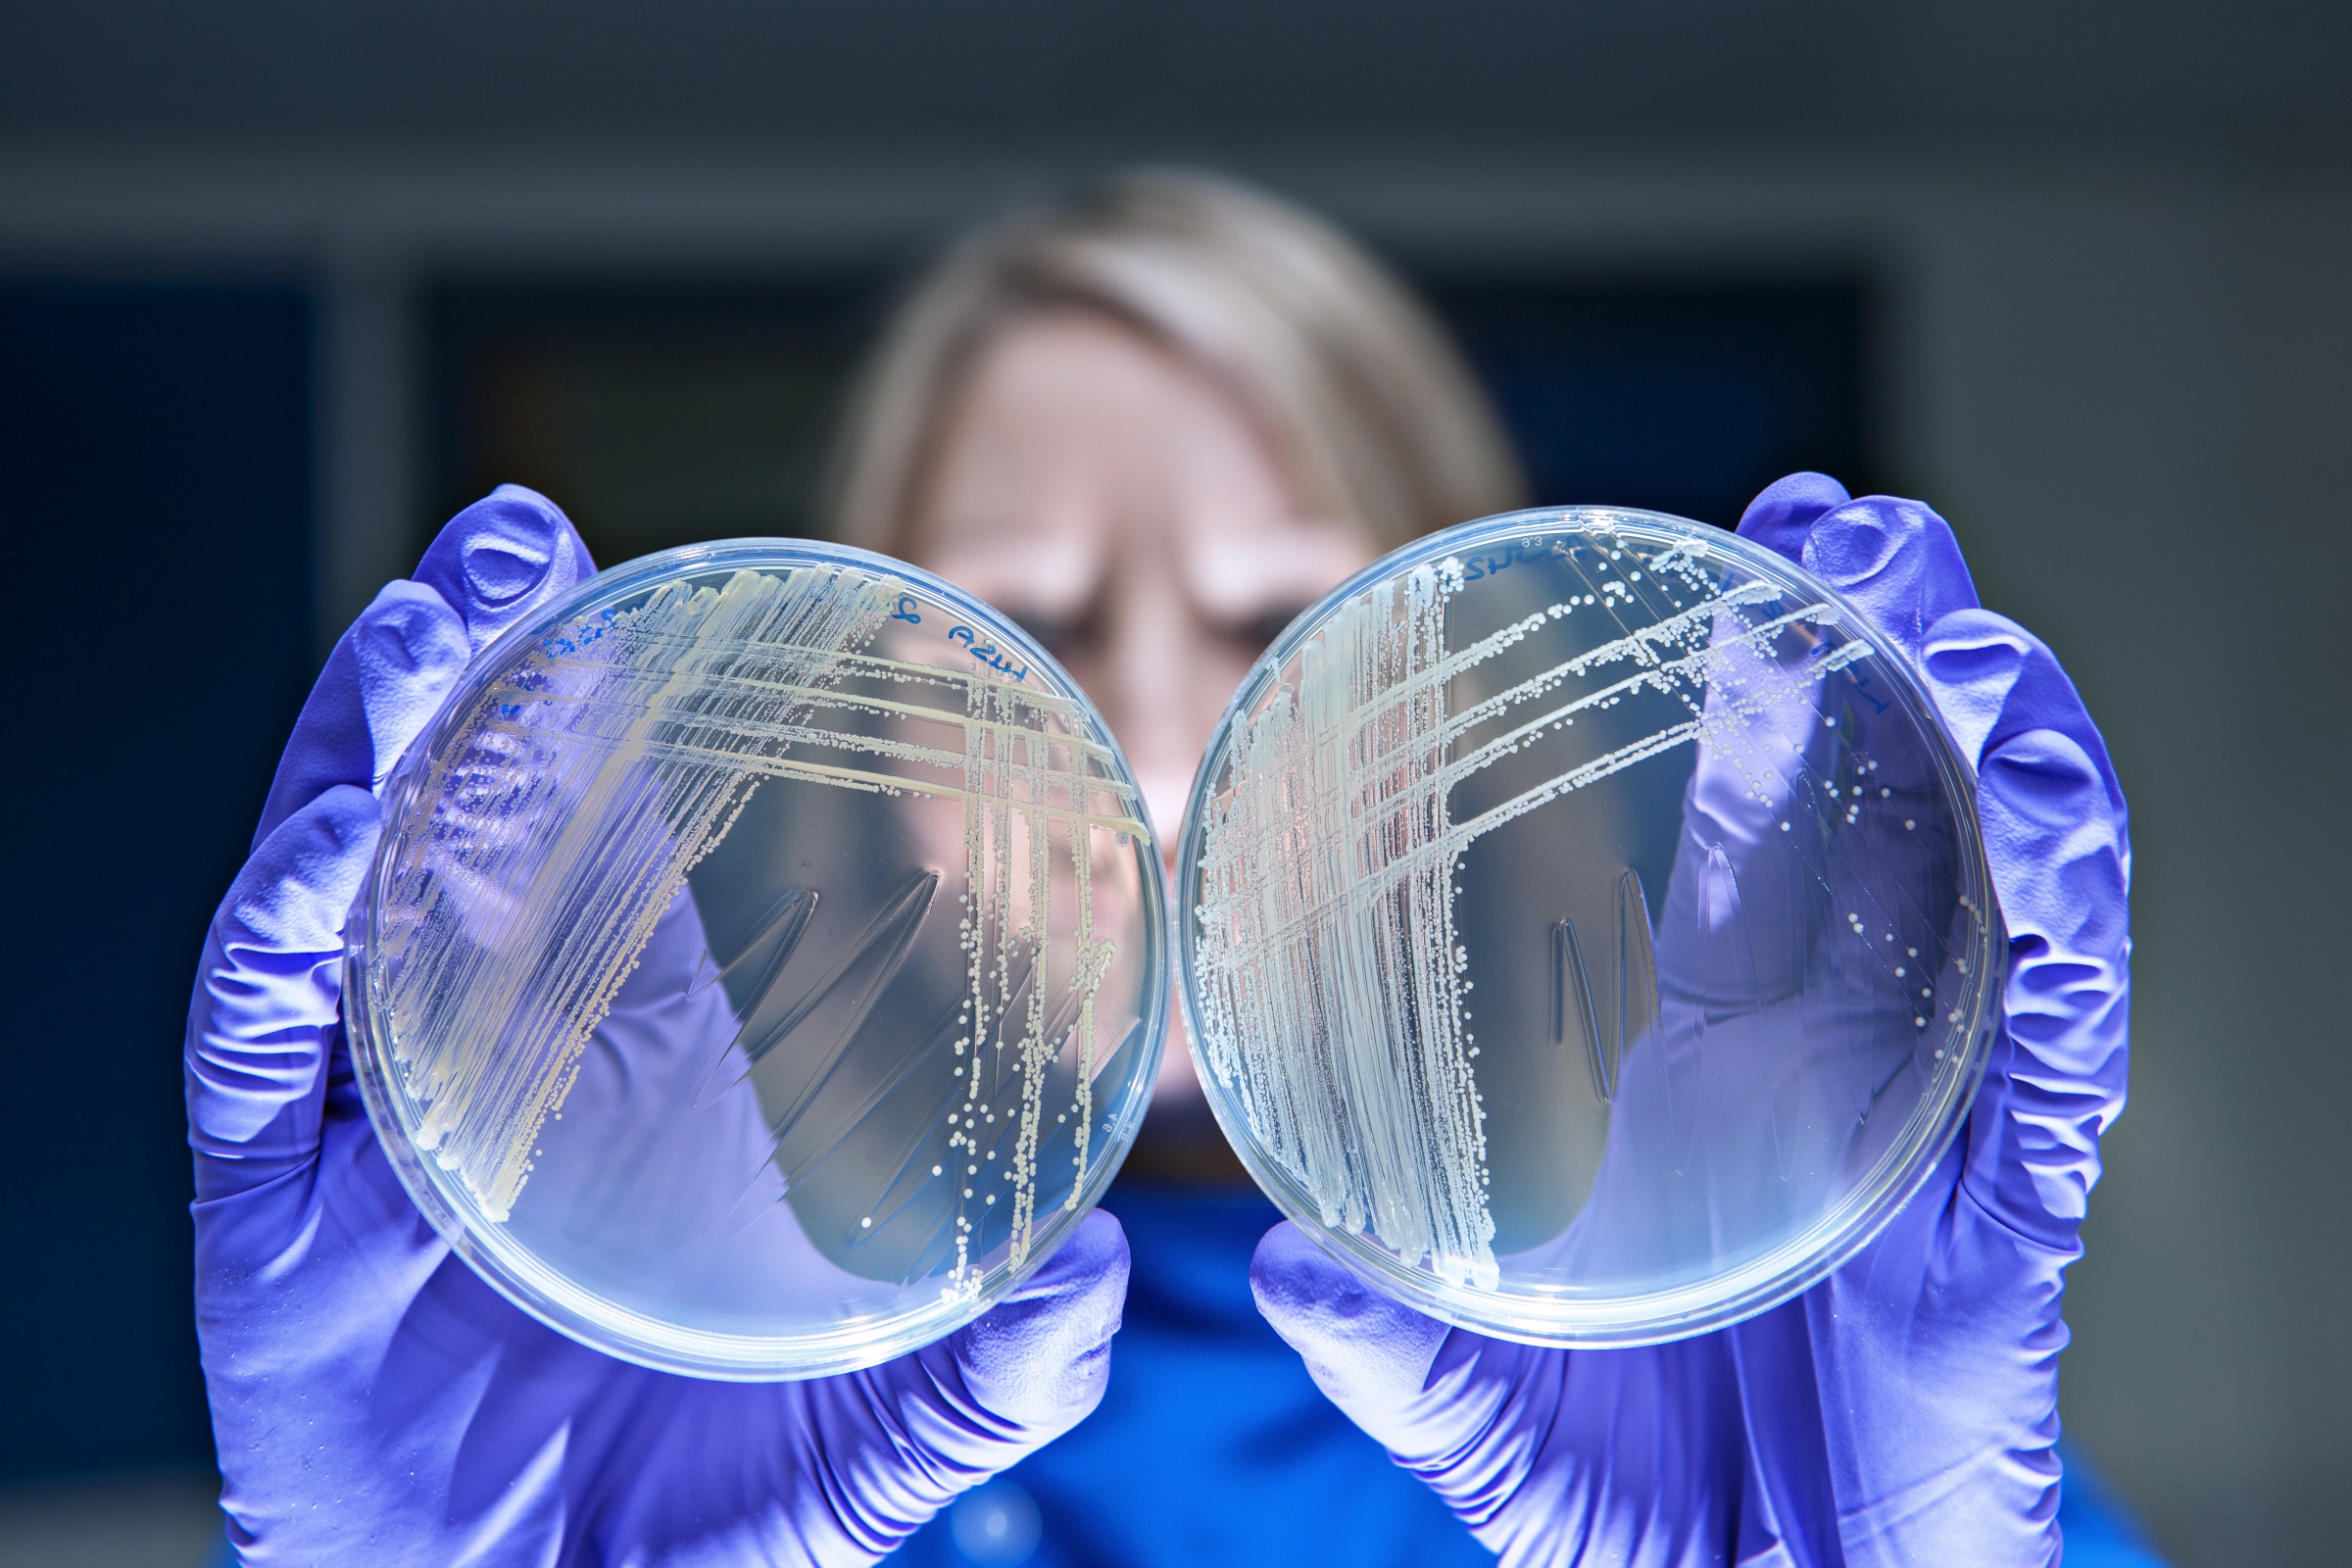
אחד הסיכונים הגדולים ביותר לבריאות האדם. תרביות של חיידקים עמידים לאנטיביוטיקה | צילום: Science Photo Library

מצד אחד נמצאים חוקרים ורופאים, ומצד שני – חיידקים מחוללי מחלות. המלחמה נמשכת כבר מראשית האנושות, ובאמצע המאה ה-20 היה נראה שהיא עומדת להסתיים סוף סוף, בניצחון מוחץ של הרפואה על המחלות הזיהומיות. הנשק שקרב אותנו לניצחון היה כמובן האנטיביוטיקה שבזכותה מחלות מסכנות חיים הפכו ללא יותר ממטרד של כמה ימים. אבל החיידקים לא רק שלא הוכרעו, אלא החלו להשיב מלחמה: הם פיתחו עמידות לאנטיביוטיקה וכיום מתגלים יותר ויותר זנים שאיננו מסוגלים להשמיד בשום תרופה.
מרוץ החימוש הזה ביננו לבין החיידקים נמשך, והחוקרים אינם מצליחים לפתח סוגי אנטיביוטיקה חדשים ויעילים באותה מהירות שבה מתפתחת אצל החיידקים עמידות נגד האנטיביוטיקה. ארגון הבריאות העולמי (WHO) מציין את העמידות לאנטיביוטיקה כאחד הסיכונים הגדולים ביותר לבריאות העולם, ומזהיר מפני "היום שאחרי האנטיביוטיקה", שבו שוב ימותו אנשים מזיהומים הנחשבים היום קלים.
לצד גישות חדשניות שונות, כמו טיפול בנגיפים התוקפים חיידקים ואפילו שימוש בזרם חשמלי נוסף על האנטיביוטיקה, חוקרים רבים מנסים למצוא סוגי אנטיביוטיקה שלא השתמשנו בהם בעבר, שיוכלו לכל הפחות לשמש אותנו לזמן מה. חוקרים מאוניברסיטת רוקפלר בניו-יורק, מצאו סוג חדש של אנטיביוטיקה שמייצרים חיידקי קרקע.
זה אולי נראה מוזר שהמקור לתרופה נגד חיידקים הוא דווקא חיידק, אך זה אינו יוצא דופן. חיידקים נלחמים אלה באלה, וכן במיקרואורגניזמים אחרים כמו פטריות, על מזון ומשאבים נוספים. מי שיוכל לייצר חומרים שפוגעים במתחריו יהיה בעל סיכוי גבוה יותר לנצח, וכך פיתחו רבים מהם חומרים הורגי חיידקים (שאינם הורגים אותם עצמם). פניצילין בודד מעובש, שהוא סוג של פטריה, ויש סוגי אנטיביוטיקה בהם אנו משתמשים כיום, כמו פולימיקסין b וגנטמיצין, שמקורם בחיידקים.
החיידקים שמהם הפיקו אנטיביוטיקה גודלו כמעט תמיד בתרבית במעבדה. עם תרביות קל יחסית לעבוד – אפשר לגדל את החיידקים בכמויות גדולות, כך שנוח להפיק מהם חומרים שונים. אבל נראה שכבר הוצאנו ממקור זה כל מה שהיה אפשר להוציא, וכיום כבר כמעט לא מתבצעים ניסויים שמטרתם לגלות חומרים אנטיביוטיים חדשים בחיידקים כאלו. במחקר החדש החליטו החוקרים לחפש חיידקי קרקע מייצרי אנטיביוטיקה בלי לגדל אותם קודם לכן, משום שחיידקים רבים הקיימים באופן טבעי בקרקע אינם גדלים היטב בתנאי מעבדה.
אחד הסיכונים הגדולים לבריאות האדם. תרביות של חיידקים עמידים לאנטיביוטיקה | צילום: Science Photo Library
מחפשים גֵנים באדמה
החוקרים אספו דגימות קרקע מיותר מאלף מקומות בארצות הברית, ובעזרת שיטה שפיתחו, קבעו את רצף ה-DNA של החיידקים באדמה. הם חיפשו רצף מסוים שמצוי בגנים האחראים לייצור משפחה מוכרת של אנטיביוטיקה חיידקית, וגילו בחיידקי קרקע גנים שהכיל רצף דומה לזה שהכירו. החוקרים קיוו כי החלבונים שמייצרים הגנים האלו יוכלו לשמש גם הם כאנטיביוטיקה. הם קראו למשפחה החדשה של החלבונים "מלאצידין" (malacidin).
כדי לבדוק אם לחלבונים האלו אכן יש פעילות אנטיביוטית אפקטיבית, הם הינדסו חיידקים שאפשר לגדל בקלות במעבדה לייצר את החלבונים האלו, והשתמשו בהם נגד חיידקי סטפילוקוקוס (Staphylococcus) עמידים לאנטיביוטיקה.
כשהשתמשו במלאצידין לטיפול בעכברים בעלי פצעים מזוהמים בחיידקי סטפילוקוקוס עמידים, התרופה השמידה לחלוטין את החיידקים. לא פחות חשוב, לא נראתה שום פגיעה בתאים של העכברים עצמם, גם במינון הגבוה ביותר של התרופה.
איך המלאצידין הורג את החיידקים? החוקרים מצאו שהוא מפרק מרכיב מרכזי בדופן התא של החיידקים, מבנה המעניק להם הגנה ובלעדיו הם לא יכולים לשרוד. לתאים של בעלי חיים אין דופן תא, ולכן המלאצידין אינו מזיק להם.
כדי לבדוק כמה מהר יכולה להתפתח עמידות לאנטיביוטיקה החדשה, חשפו החוקרים חיידקים למינונים נמוכים של מלאצידין שאינם מספיקים בשביל להרוג. לאחר חשיפה של 20 יום עדיין לא נראתה כל עמידות, ממצא מעודד מאוד למרות שהוא כמובן לא מבטיח שלא תתפתח עמידות בהמשך. החוקרים מציינים שחיידקים הנמצאים בקרקע חשופים כל יום לתחרות עזה מצד חיידקים אחרים, ויש סיכוי שאותו מרוץ חימוש דחף אותם לפתח אנטיביוטיקה שקשה מאוד להתמודד עמה.
פיתוח המלאצידין נמצא עדיין בשלב מוקדם. יידרש עוד זמן רב כדי לברר אם הוא יוכל לשמש אנטיביוטיקה לטיפול בני אדם ומה תהיה יעילותו. החוקרים מקווים כמובן שהוא ישמש פתרון, גם אם זמני, לחולים המתמודדים עם חיידקים עמידים. כמו כן הם מקווים שהשיטה שפיתחו תעזור למצוא עוד ועוד סוגים חדשים של אנטיביוטיקה יעילה.